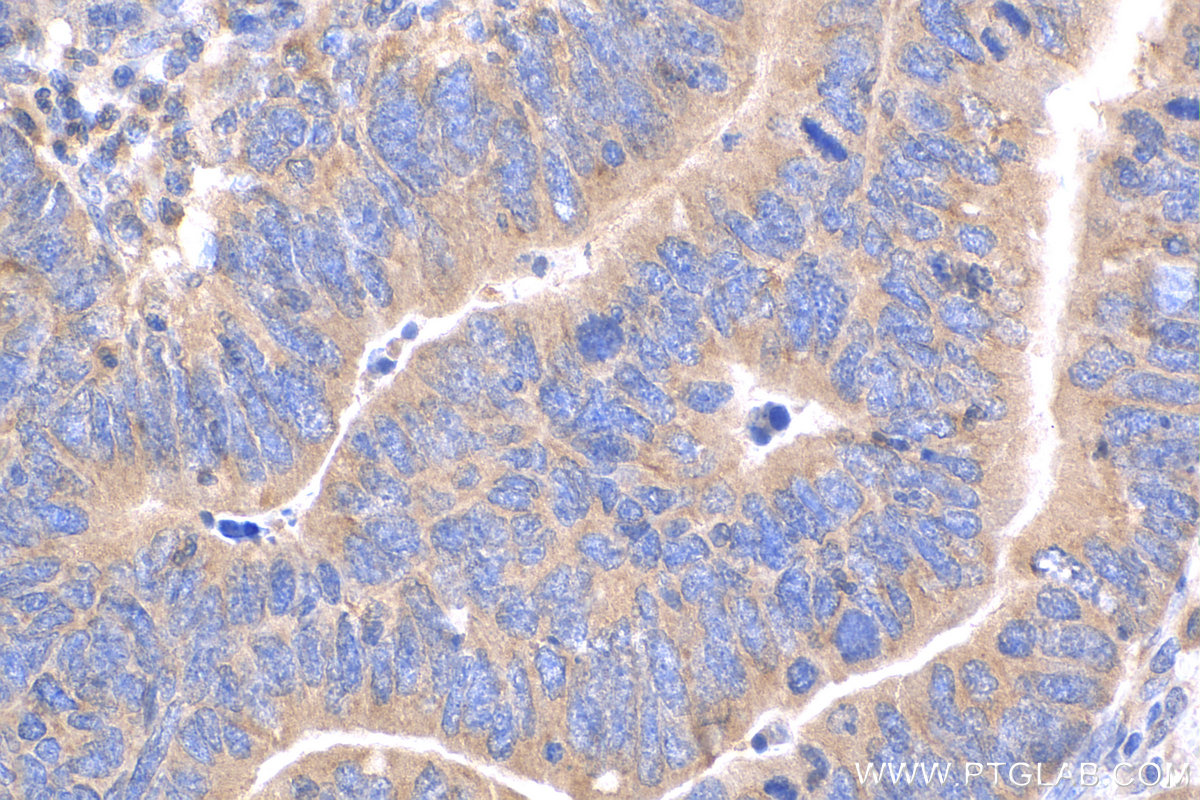
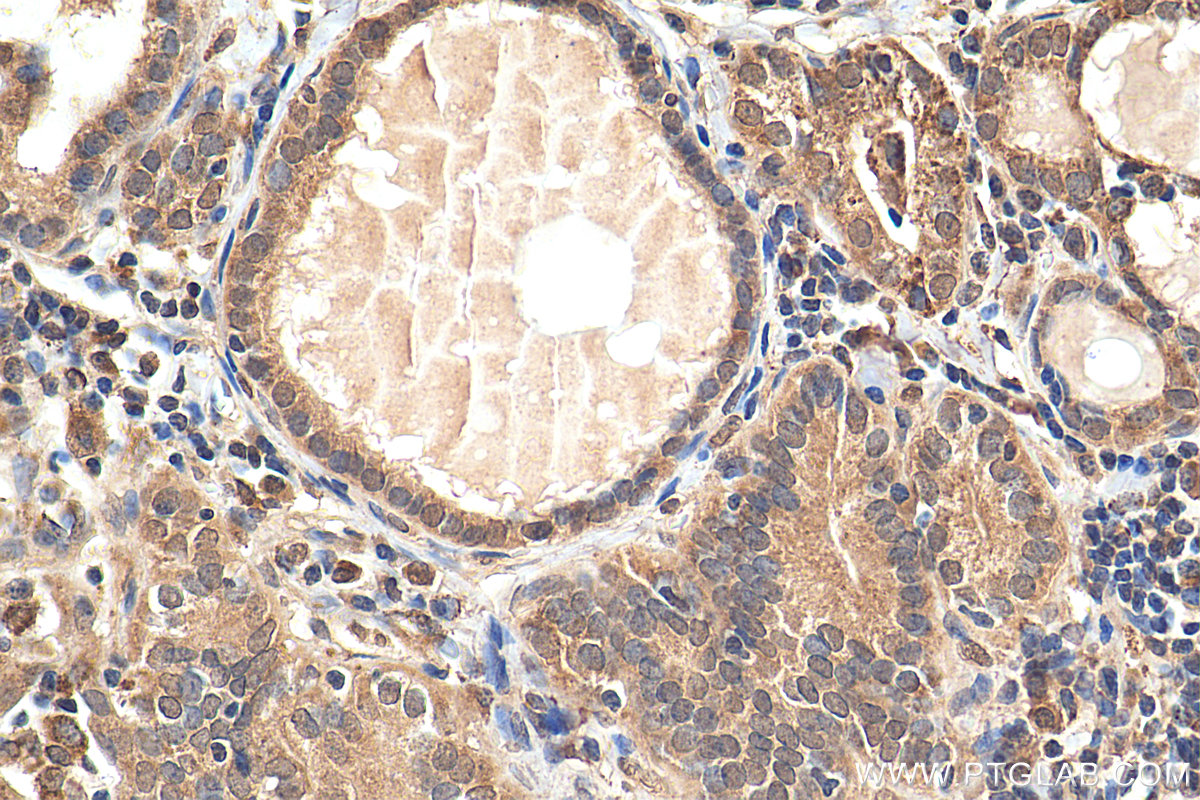

验证数据展示
经过测试的应用
| Positive WB detected in | Tunicamycin treated HeLa cells, MCF-7 cells, HeLa cells, K-562 cells, RAW 264.7 cells |
| Positive IP detected in | C6 cells |
| Positive IHC detected in | human colon cancer tissue, human breast cancer tissue, human thyroid cancer tissue, human cervical cancer tissue, mouse brain tissue Note: suggested antigen retrieval with TE buffer pH 9.0; (*) Alternatively, antigen retrieval may be performed with citrate buffer pH 6.0 |
| Positive IF/ICC detected in | Tunicamycin treated HeLa cells, thapsigargin treated U2OS cells |
| Positive FC (Intra) detected in | Tunicamycin treated HeLa cells |
Samples need to be treated with ER stress.
推荐稀释比
| 应用 | 推荐稀释比 |
|---|---|
| Western Blot (WB) | WB : 1:500-1:3000 |
| Immunoprecipitation (IP) | IP : 0.5-4.0 ug for 1.0-3.0 mg of total protein lysate |
| Immunohistochemistry (IHC) | IHC : 1:50-1:500 |
| Immunofluorescence (IF)/ICC | IF/ICC : 1:50-1:500 |
| Flow Cytometry (FC) (INTRA) | FC (INTRA) : 0.40 ug per 10^6 cells in a 100 µl suspension |
| It is recommended that this reagent should be titrated in each testing system to obtain optimal results. | |
| Sample-dependent, Check data in validation data gallery. | |
产品信息
15204-1-AP targets CHOP/GADD153 in WB, IHC, IF/ICC, FC (Intra), IP, CoIP, ChIP, ELISA applications and shows reactivity with human, mouse, rat samples.
| 经测试应用 | WB, IHC, IF/ICC, FC (Intra), IP, ELISA Application Description |
| 文献引用应用 | WB, IHC, IF, IP, CoIP, ChIP |
| 经测试反应性 | human, mouse, rat |
| 文献引用反应性 | human, mouse, rat, pig, rabbit, canine, chicken, zebrafish, hamster |
| 免疫原 |
CatNo: Ag7354 Product name: Recombinant human CHOP; GADD153 protein Source: e coli.-derived, PGEX-4T Tag: GST Domain: 1-169 aa of BC003637 Sequence: MAAESLPFSFGTLSSWELEAWYEDLQEVLSSDENGGTYVSPPGNEEEESKIFTTLDPASLAWLTEEEPEPAEVTSTSQSPHSPDSSQSSLAQEEEEEDQGRTRKRKQSGHSPARAGKQRMKEKEQENERKVAQLAEENERLKQEIERLTREVEATRRALIDRMVNLHQA 种属同源性预测 |
| 宿主/亚型 | Rabbit / IgG |
| 抗体类别 | Polyclonal |
| 产品类型 | Antibody |
| 全称 | DNA-damage-inducible transcript 3 |
| 别名 | CHOP; GADD153, CHOP, DDIT3, GADD153, C/EBP zeta |
| 计算分子量 | 19 kDa |
| 观测分子量 | 30 kDa |
| GenBank蛋白编号 | BC003637 |
| 基因名称 | CHOP |
| Gene ID (NCBI) | 1649 |
| RRID | AB_2292610 |
| 偶联类型 | Unconjugated |
| 形式 | Liquid |
| 纯化方式 | Antigen affinity purification |
| UNIPROT ID | P35638 |
| 储存缓冲液 | PBS with 0.02% sodium azide and 50% glycerol, pH 7.3. |
| 储存条件 | Store at -20°C. Stable for one year after shipment. Aliquoting is unnecessary for -20oC storage. |
背景介绍
CHOP, also known as GADD153 or DDIT3, is a highly conserved gene in both the structural and regulatory regions. Imposed by unfolded and misfolded proteins, CHOP is significantly induced by ER stress. CHOP is considered a proapoptotic marker of ER stress dependent cell death. CHOP acts as a dominant-negative inhibitor of the transcription factor C/EBP and LAP. It may play an important role in the malignant transformation of nevus to melanoma. The calculated molecular weight of CHOP is 19 kDa, but the protein migrates on an SDS-PAGE gel with an observed molecular mass of 29 kDa (PMID: 1547942).
实验方案
| Product Specific Protocols | |
|---|---|
| IF protocol for CHOP/GADD153 antibody 15204-1-AP | Download protocol |
| IHC protocol for CHOP/GADD153 antibody 15204-1-AP | Download protocol |
| IP protocol for CHOP/GADD153 antibody 15204-1-AP | Download protocol |
| WB protocol for CHOP/GADD153 antibody 15204-1-AP | Download protocol |
| Standard Protocols | |
|---|---|
| Click here to view our Standard Protocols |
发表文章
| Species | Application | Title |
|---|---|---|
Nat Immunol Exosomes mediate the cell-to-cell transmission of IFN-α-induced antiviral activity. | ||
Mol Cell Mitochondrial DNA breaks activate an integrated stress response to reestablish homeostasis | ||
Mol Cell The FUS::DDIT3 fusion oncoprotein inhibits BAF complex targeting and activity in myxoid liposarcoma. | ||
Mol Cell Filamentous GLS1 promotes ROS-induced apoptosis upon glutamine deprivation via insufficient asparagine synthesis. |